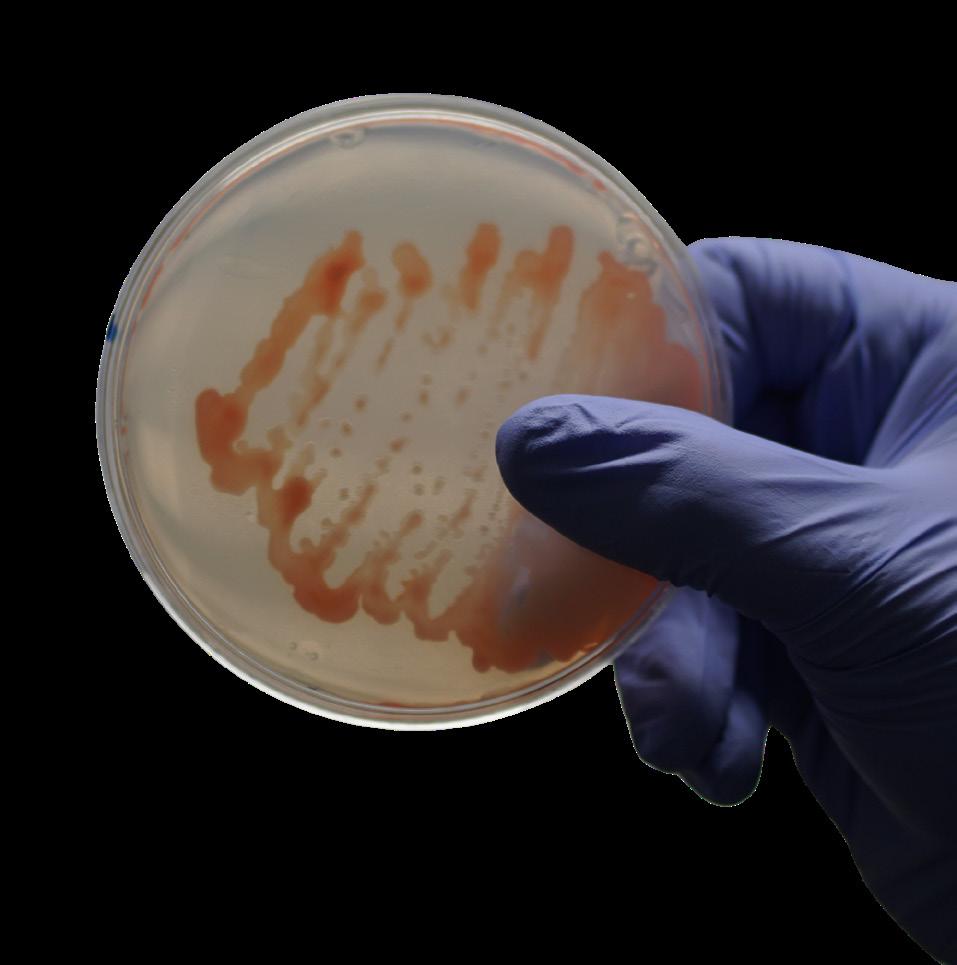

Leading the way in Biosolutions individually tailored for crops. Clayton NUE™.



Leading the way in Biosolutions individually tailored for crops. Clayton NUE™.
What is Clayton NUE?
A new Biosolutions product range containing Plant Growth Promoting Rhizobacteria (PGPR) for most key arable and veg crops.
NUE™ utilises PGPR to provide better Nutrient Use Efficiency (NUE) for a wide range of arable crops, increasing yield and reducing input costs.
What are Plant Growth Promoting Rhizobacteria (PGPR)?
A small but highly functional group of beneficial bacteria that multiplies in the soil when applied to aid the acquisition and conversion of residual and applied nutrients into plant available forms.
How does Clayton NUE improve nutrient use efficiency?
PGPRs are amongst the most functionally important soil micro-organisms in soils. Selected correctly, consortia of these beneficial bacteria can fix nitrogen from the air, slow down its mobility in soils, produce organic acids to release phosphorus and potassium and produce critical plant hormones that trigger top and root / tuber growth in treated crops. In concert these function increase the nutrient use efficiency of soils improving the flow residual and applied nutrition into treated crops.
Incorporating Clayton NUE into spring crop management and annual rotation planning ensures a sustained improvement in soil health, nutrient availability and crop performance over successive planting cycles, leading to more sustainable and productive agricultural practices over time. This in turn will lead to healthier soils, plants and maximised yields.
The wider benefits of NUE biosolutions
• Improved crop yield and quality
• Improved root and shoot development through production of plant phytohormones
• Reduced reliance on synthetic nitrogen fertiliser inputs
• Increased availability and uptake of nitrogen, phosphorus and other vital nutrients
• Builds healthier, biologically active soils
• Improved plant vigour for better disease resistance
Rhizobacteria improve soil health around the rooting zone and help with promoting crop development, enhanced nutrition and plant protection.
Enhanced nutrition for better Nutrient Use Efficiency, N fixation, P solubilisation and increased iron uptake.
Crop Development is boosted from using PGPRs through their production of phytohormones, stimulating top growth & root development in the crop.
Plant Protection is improved with competitive exclusion of pathogens and greater induced systemic resistance.

Taking a closer look at Biosolutions.
Bio fertilisers contain living micro-organisms which, when applied to plant surfaces or soil, colonise the plant root zone or “rhizosphere”. Here they feed on plant exudates and multiply, increasing their value to soils until the community of soil organisms ‘balances’ in to a revitalised steady state.
Healthy soils are full of naturally occurring beneficial soil micro-organisms including mycorrhizal fungi and plant growth promoting rhizobacteria (PGPR). As well as supporting host plants, these microbes also promote a healthy soil community of living organisms including protozoa, nematodes, arthropods, insects and earthworms as well as other fungi and bacteria. These living organisms play critical roles in balancing soil chemistry as well as the biological elements of healthy soils.
A biologically active soil will help farmers to reduce fertiliser inputs, increase plant health, enhance yields and mitigate abiotic and biotic stresses such as drought and diseases. Through the use of suitable biologically active products in agricultural crops, farmers can enhance the vast microbial resources within soils to increase mineralisation, transport and use of soil nutrients for more sustainable farming.
In order to gain the most benefits, careful crop management is recommended. Typically less then 5-10% of applied phosphorus is directly available to the treated crop, the rest is retained by the soil. Between 50% and 75% of the nitrogen applied to the field is not used by the plant and is lost by leaching into the soil.
Beneficial soil micro-organisms are able to improve soil fertility by metabolising both phosphorus and nitrogen whilst significantly increasing their plant availability.
A crop’s ability to extract these resources is directly affected by the levels of microbial activity and diversity in the soil. This acts to both chemically alter and release locked nutrients to make them plant available.
After correct application of NUE products the microbial activity in soil is increased and leads to enhanced crop efficiency at extracting soilbound fertilisers.
Common farming practices, such as ploughing, mono cropping and low biodiverse rotations can act to disrupt soil microbiota.
NUE products can help to restore the microbial balance in all soils, and particularly those impeded or damaged by conventional farming techniques or cultivation practices.
Spray applied in the spring on winter and spring sown crops, the addition of a burst of highly tuned PGPR can adjust the microbiome for the target crop.

NUE™ plant growth promoting rhizobacteria products are formulated & tested in the UK to improve soil health and plant efficiency for better nutrient and water uptake.
NUE Biosolutions are produced for Clayton in the UK by PlantWorks in their facilities based at the Kent Science Park, one of the leading UK resources for biofertilisers. Our products are developed by qualified mycologists, bacteriologists and horticulturalists in collaboration with leading academic and research institutions.
Quality assurance is core to microbial production for NUE products, and operates to GMP standard, using defined SOPs with third party validation, including regular DNA profiling of bacterial strains.
An important group of biofertilisers are PGPR, these bacteria have the ability to fix atmospheric nitrogen and unlock soil-bound phosphorus and potassium. The bacteria work in synergy with mycorrhizal fungi, present in soils, allowing for efficient transport of released nutrients to the plant. Additionally, PGPRs support a robust plant immune system for healthier crops and produce phytohormones such as auxins and cytokinins, aiding growth and development of plants.
Healthy soil contains billions of bacteria from thousands of species, some of which promote the growth and health of plants and are collectively known as Plant Growth Promoting Rhizobacteria. These bacteria live around the root zone and interact with plants symbiotically.
• Fix nitrogen
• Solubilise phosphorus
• Produce natural plant hormones
• Increase plant available nutrients and uptake
• Contribute to organic matter
• Support all crops in rotations
• Help degrade organic soil pollutants in the plant root zone (rhizoremediation)
• Improve root development
• Improve plant resistance against stress
Production of plant hormones
Plant Growth Promoting Rhizobacteria produce a number of hormones that promote growth and stress resiliences including;
Cytokinine – for shoot growth
Auxins – for root growth
Gibberellins – to stimulate cell elongation
Abscissic acid – helps a plant under drought stress
Nitrogen and phosphorus are two of the three macronutrients that crops require in large amount to grow. Over 78% of the atmosphere is composed of N, but in this gaseous form it is not usable by plants. Some rhizobacteria have enzymes (similar to the rhizobia that work in leguminous plants) to convert the atmospheric N into plant available NH4+, which is excreted into the rhizosphere for the plants to take up.
Similar to mycorrhizal fungi, these rhizobacteria release powerful chemicals into the soil that dissolve hard to capture nutrients such as phosphorus, iron and other “tightly bound” soil nutrients. In exchange for all these accessible nutrients from the bacteria, the plants provide the bacteria with photosynthesised carbon source and other organic nutrients.
Natural boost to a plant’s immunity
A healthy crop plant requires a beneficial microflora like these plant growth promoting rhizobacteria as well as mycorrhizal fungi. The presence of beneficial microbes will help compete out potential plant pathogens as well as boosting a plant’s natural immunity.
Beneficial PGPR
Beneficial PGPR

Introducing the Clayton NUE product range 2024.
NUE products can be deployed to aid early establishment and increase grain potential as Liquid Formulations for spray application directly to ground or a young crop.
Each individual NUE formulation contains two Actives:
PGPR + Biostimulant
Treatment area per unit pack: 5 Hectare (~12.5 Acres).
All NUE PGPR microbes are produced and carefully quality controlled by PlantWorks Ltd. NUE bacterial products contain targeted blends of up to 4 species of PGPR per product. Bacteria are selected for optimum performance with specific crop types to ensure maximum benefits for on-farm use.

Plant Growth Promoting Rhizobacteria to increase Nutrient Use Efficiency making macro and micro nutrients more plant available and stimulating phytohormone production.
 beet
beet
Pack contents
4 pouches of 50ml bioinoculant containing rhizobacteria spp:
• Bacillus amyloliquefaciens
• Rhizobium laguerreae
• Azospirillum brasilense
• Phyllobacterium myrsinacearum
1 litre of biostimulant - food source for bacteria.
1 sachet of dechlorination agent.
Area treated per pack
5 ha
Time of application
Early Spring, GS1 ‘Leaf development’. Apply post emergence from 2-4 true leaves.
Minimum
200L/ha
Note: Application timings are a guide based on when conditions are likely to be most favourable. Growth stages are approximate and may vary depending on the weather conditions and agricultural practices.
Conditions of use:
Water
If tank water is chlorinated add in the dechlorination sachet before adding the bioinoculant.
Apply when soil temperatures are a minimum of 8°C (and increasing). Apply when day temperature will reach minimum 10°C and maximum 25°C, and the night temperature minimum 5°C.
Crop condition
Apply post germination, during active growth, when there is not too much leaf cover and there is still access to the soil to maximise product penetration.
Note: Avoid spraying on dry soil or under excessive sunlight. The best results are obtained when spray is applied on moist soils (early morning or late afternoon).
Product can be applied alone or with specified tank mixes.
The following additives have been tested to be compatible with Clayton NUE Beet. For best results, bacteria should be sprayed using medium to coarse droplets. Using fine mist may reduce product function.
For information on mixing and handling instructions, storage, safety information and sprayer cleaning, please see page 22. Always read the label and product information before use. For further information on this product please contact us or scan the QR code.
Apply tank mixes at filling stage 2, when tank is half filled. Agitate before adding Clayton NUE to the sprayer tank.
DO NOT apply foliar Nitrogen 3 days before or after application of Clayton NUE.
Compatible with the following combination of active ingredients: - Sugar Beet only
Metamitron, Phenmediphan, Triflusulfuron, Ethofumasate.
Any mixtures should be applied as soon as possible after preparation and within 6 hours.

Plant Growth Promoting Rhizobacteria to increase Nutrient Use Efficiency making macro and micro nutrients more plant available and stimulating phytohormone production.
 Maize maize
Maize maize
Pack contents
3 pouches of 50ml bioinoculant containing rhizobacteria spp:
• Bacillus amyloliquefaciens
• Rhizobium sp
• Azospirillum brasilense
1 litre of biostimulant - food source for bacteria.
1 sachet of dechlorination agent. COMPATIBILITY
Area treated per pack
5 ha
For information on mixing and handling instructions, storage, safety information and sprayer cleaning, please see page 22.
Time of application
Early Spring, GS1 ‘Leaf development’. Apply post emergence from 1-3 true leaves.
Minimum 200L/ha
Note: Application timings are a guide based on when conditions are likely to be most favourable. Growth stages are approximate and may vary depending on the weather conditions and agricultural practices.
Water
If tank water is chlorinated add in the dechlorination sachet before adding the bioinoculant.
Apply when soil temperatures are a minimum of 8°C (and increasing). Apply when day temperature will reach minimum 10°C and maximum 25°C, and the night temperature minimum 5°C.
Crop condition
Apply post germination, during active growth, when there is not too much leaf cover and there is still access to the soil to maximise product penetration.
Note: Avoid spraying on dry soil or under excessive sunlight. The best results are obtained when spray is applied on moist soils (early morning or late afternoon).
Product can be applied alone or with specified tank mixes.
The following additives have been tested to be compatible with Clayton NUE Maize. For best results, bacteria should be sprayed using medium to coarse droplets. Using fine mist may reduce product function.
Apply tank mixes at filling stage 2, when tank is half filled. Agitate before adding Clayton NUE to the sprayer tank.
DO NOT apply foliar Nitrogen 3 days before or after application of Clayton NUE.
Compatible with the following combination of active ingredients:
Herbicides
Nicosulfuron, Mesotrione.
Any mixtures should be applied as soon as possible after preparation and within 6 hours.
BIOSOLUTION

Plant Growth Promoting Rhizobacteria to increase Nutrient Use Efficiency making macro and micro nutrients more plant available and stimulating phytohormone production.
 Spring Oilseed Rape Winter Oilseed Rape
Spring Oilseed Rape Winter Oilseed Rape
Pack contents
4 pouches of 50ml bioinoculant containing rhizobacteria spp:
• 2 x Phyllobacterium brassicacearum
• 2 x Phyllobacterium bourgognense
1 litre of biostimulant - food source for bacteria.
1 sachet of dechlorination agent.
Area treated per pack
5 ha
For information on mixing and handling instructions, storage, safety information and sprayer cleaning, please see page 22.
Time of application
Early Spring GS1 ‘Leaf development’ and GS3 ‘Stem development’.
Note: Application timings are a guide based on when conditions are likely to be most favourable. Growth stages are approximate and may vary depending on the weather conditions and agricultural practices.
Conditions of use:
Water
If tank water is chlorinated add in the dechlorination sachet before adding the bioinoculant.
Apply when soil temperatures are a minimum of 8°C (and increasing). Apply when day temperature will reach minimum 10°C and maximum 25°C, and the night temperature minimum 5°C.
Crop condition
Apply post germination, during active growth, when there is not too much leaf cover and there is still access to the soil to maximise product penetration.
Note: Avoid spraying on dry soil or under excessive sunlight. The best results are obtained when spray is applied on moist soils (early morning or late afternoon).
Product can be applied alone or with specified tank mixes.
The following additives have been tested to be compatible with Clayton NUE Oilseed Rape. For best results, bacteria should be sprayed using medium to coarse droplets. Using fine mist may reduce product function.
Apply tank mixes at filling stage 2, when tank is half filled. Agitate before adding Clayton NUE to the sprayer tank.
DO NOT apply foliar Nitrogen 3 days before or after application of Clayton NUE.
Compatible with the following combination of active ingredients:Oilseed rape only
Prothioconazole, Tebuconazole.
read the label and product information before use. For further information on this product please contact us or scan the QR code.

Plant Growth Promoting Rhizobacteria to increase Nutrient Use Efficiency making macro and micro nutrients more plant available and stimulating phytohormone production.
 Onions Leeks
onions & leeks
Onions Leeks
onions & leeks
Pack contents
3 pouches of 50ml bioinoculant containing rhizobacteria spp:
• Bacillus amyloliquefaciens
• Azospirillum brasilense
• Phyllobacterium myrsinacearum
1 litre of biostimulant - food source for bacteria.
1 sachet of dechlorination agent.
Area treated per pack
5 ha
For information on mixing and handling instructions, storage, safety information and sprayer cleaning, please see page 22.
ONIONS & LEEKS
Time of application
Early Spring, GS1 ‘Leaf development’. Apply post emergence.
Minimum 200L/ha
Note: Application timings are a guide based on when conditions are likely to be most favourable. Growth stages are approximate and may vary depending on the weather conditions and agricultural practices.
Conditions of use:
Water
If tank water is chlorinated add in the dechlorination sachet before adding the bioinoculant.
Apply when soil temperatures are a minimum of 8°C (and increasing). Apply when day temperature will reach minimum 10°C and maximum 25°C, and the night temperature minimum 5°C.
condition
Apply post germination, during active growth, when there is not too much leaf cover and there is still access to the soil to maximise product penetration.
Note: Avoid spraying on dry soil or under excessive sunlight. The best results are obtained when spray is applied on moist soils (early morning or late afternoon).
Add contents of water treatment sachet to tank.
Half fill tank with clean water.
Shake bioinoculant sachets thoroughly and add to the tank. Add biostimulant to the tank.
Top up tank with clean waterwe recommend a minimum of 200L/ha.
Agitate during application. At the end of application, flush through any residue with clean water (see sprayer cleaning procedure).
Always read the label and product information before use. For further information on

Plant Growth Promoting Rhizobacteria to increase Nutrient Use Efficiency making macro and micro nutrients more plant available and stimulating phytohormone production.
 Potatoes Carrots
Potatoes Carrots
Pack contents
4 pouches of 50ml bioinoculant containing rhizobacteria spp:
• Bacillus amyloliquefaciens
• Rhizobium laguerreae
• Azospirillum brasilense
• Gluconacetobacter diazotrophicus
1 litre of biostimulant - food source for bacteria.
1 sachet of dechlorination agent.
Area treated per pack
5 ha
For information on mixing and handling instructions, storage, safety information and sprayer cleaning, please see page 22.
Time of application
GS1 ‘Leaf development’. Apply post emergence.
Minimum 200L/ha
Note: Application timings are a guide based on when conditions are likely to be most favourable. Growth stages are approximate and may vary depending on the weather conditions and agricultural practices.
Conditions of use:
Water
If tank water is chlorinated add in the dechlorination sachet before adding the bioinoculant.
Apply when soil temperatures are a minimum of 8°C (and increasing). Apply when day temperature will reach minimum 10°C and maximum 25°C, and the night temperature minimum 5°C.
Crop condition
Apply post germination, during active growth, when there is not too much leaf cover and there is still access to the soil to maximise product penetration.
Note: Avoid spraying on dry soil or under excessive sunlight. The best results are obtained when spray is applied on moist soils (early morning or late afternoon).
Add contents of water treatment sachet to tank.
Half fill tank with clean water.
Shake bioinoculant sachets thoroughly and add to the tank. Add biostimulant to the tank.
Top up tank with clean waterwe recommend a minimum of 200L/ha.
Agitate during application. At the end of application, flush through any residue with clean water (see sprayer cleaning procedure).
Always read the label and product information before use. For further information on this product please contact us or scan the QR code.

Plant Growth Promoting Rhizobacteria to increase Nutrient Use Efficiency making macro and micro nutrients more plant available and stimulating phytohormone production.

Pack contents
4 pouches of 50ml bioinoculant containing rhizobacteria spp:
• Bacillus amyloliquefaciens
• Derxia lacustris
• Rhizobium sp
• Gluconacetobacter diazotrophicus
1 litre of biostimulant - food source for bacteria.
1 sachet of dechlorination agent.
Area treated per pack
5 ha
For information on mixing and handling instructions, storage, safety information and sprayer cleaning, please see page 22.
Conditions of use:
SPRING WHEAT
Time of application
GS13-19. Apply postemergence until early stem elongation. Minimum 200L/ha WINTER WHEAT
Time of application
GS25-31. Apply when the crop is at late tillering / early stem elongation stage.
Note: Application timings are a guide based on when conditions are likely to be most favourable. Growth stages are approximate and may vary depending on the weather conditions and agricultural practices.
Water
If tank water is chlorinated add in the dechlorination sachet before adding the bioinoculant.
Temperature
Apply when soil temperatures are a minimum of 8°C (and increasing). Apply when day temperature will reach minimum 10°C and maximum 25°C, and the night temperature minimum 5°C.
Crop condition
Apply post germination, during active growth, when there is not too much leaf cover and there is still access to the soil to maximise product penetration.
Note: Avoid spraying on dry soil or under excessive sunlight. The best results are obtained when spray is applied on moist soils (early morning or late afternoon).
Product can be applied alone or with specified tank mixes. The following additives have been tested to be compatible with Clayton NUE Wheat. For best results, bacteria should be sprayed using medium to coarse droplets. Using fine mist may reduce product function.
Apply tank mixes at filling stage 2, when tank is half filled. Agitate before adding Clayton NUE to the sprayer tank.
DO NOT apply foliar Nitrogen 3 days before or after application of Clayton NUE.
Compatible with the following combination of active ingredients:
Herbicides
MCPA, Florasulam, Pyroxsulam, Metsulfuron, Thifensulfuron, Tribenuron, Iodosulfuron, Mesosulfuron, Fluroxypyr.
Fungicides
Folpet, Bixafen, Fluropyram, Tebuconazole.
PGRs
Chlormequat, Trinexapac.
Any mixtures should be applied as soon as possible after preparation and within 6 hours.

Storage
Keep out of the reach of children and animals. Store the product at room temperature, out of direct sunlight and in a cool, dry place.
Do not store in conditions below 0°C or above 35°C
For best results use within 6 months, but viable up to 1 year after purchase.
Do not open sachets until ready for use.
Handling and disposal
Before opening, shake bioinoculant sachets vigorously, ensuring all sediment is mixed thoroughly, especially from the corners of the sachets.
Cut open the sachets using scissors. Rinse the remaining contents of the biostimulant bottle and sachets with clean water, ensuring you pour the rinsing water into the sprayer tank.
Empty packaging should be disposed of responsibly.
Operator protection
During product handling, application, and in case of spill: Wear suitable protective clothing, protective gloves, and safety glasses.
When using DO NOT EAT OR DRINK.
Wash hands well after handling the product.
If on skin or clothing wash with soap and water.
In case of contact with eyes, rinse immediately with plenty of water and seek medical advice.
DO NOT ingest. If swallowed rinse mouth with water. Do not induce vomiting. Seek medical advice.
After application the entire sprayer (tank, boom, sump, circuit, nozzles, etc.) should be rinsed with clean water.
Find out more
Always read the label and product information before use. For further information on products in this guide please contact:
info@claytonpp.com
www.claytonpp.com
Add contents of water treatment sachet to tank. Half fill tank with clean water.
Shake bioinoculant sachets thoroughly and add to the tank. Add biostimulant to the tank.
Top up tank with clean waterwe recommend a minimum of 200L/ha.
Agitate during application. At the end of application, flush through any residue with clean water (see sprayer cleaning procedure). MIXING
